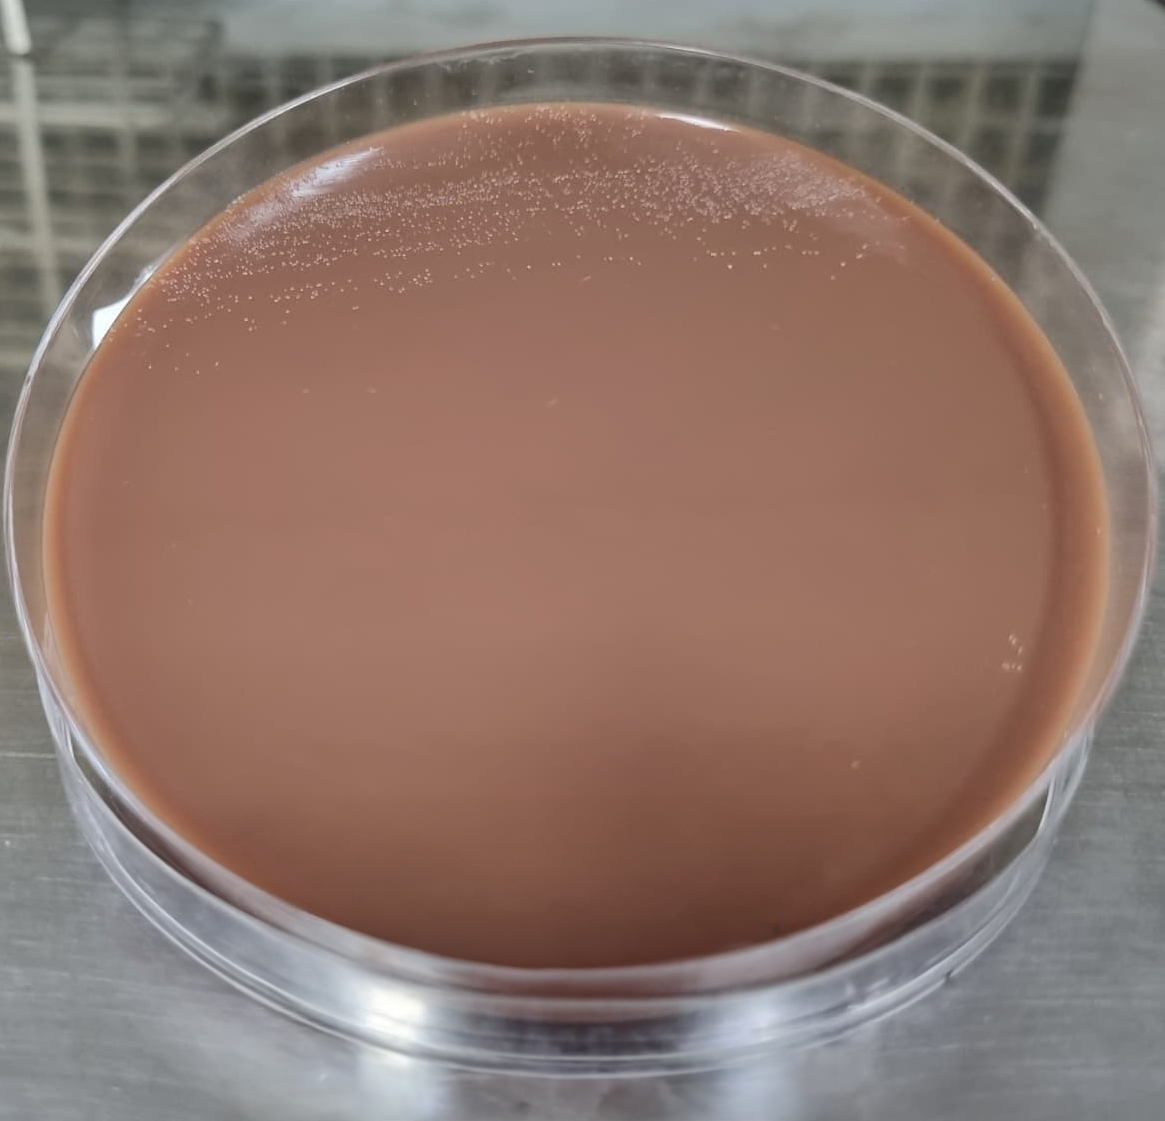

Leishmania SPP
Les presentamos el siguiente caso: hombre de 43 años, residente de una zona rural cálida con presencia de unas lesiones ulcerosas y nodulosas en sus brazos desde hacía tres meses. Pese a varios tratamientos previos con antibióticos y antiinflamatorios, las lesiones persisten y crecen.
Al examinar las muestras tomadas de las lesiones, encontramos la presencia de unos parásitos llamados “amastigotes” de Leishmania SPP.
El vector causante de la transmisión de esta enfermedad tropical es el mosquito Lutzomyia, también conocido como "mosquito de la arena". Este insecto es el trasmisor de la Leishmaniasis y se propaga principalmente en áreas rurales y de clima cálido. Para la lectura microscópica, las muestras se tomaron en láminas, se dejaron secar y se colorearon con tinción de Field (utilizada para el análisis del parásito). Se evidenciaron la presencia de estos amastigotes propios de la Leishmania, fuera de los leucocitos y ocasionalmente dentro de ellos, como se puede apreciar en las fotos.